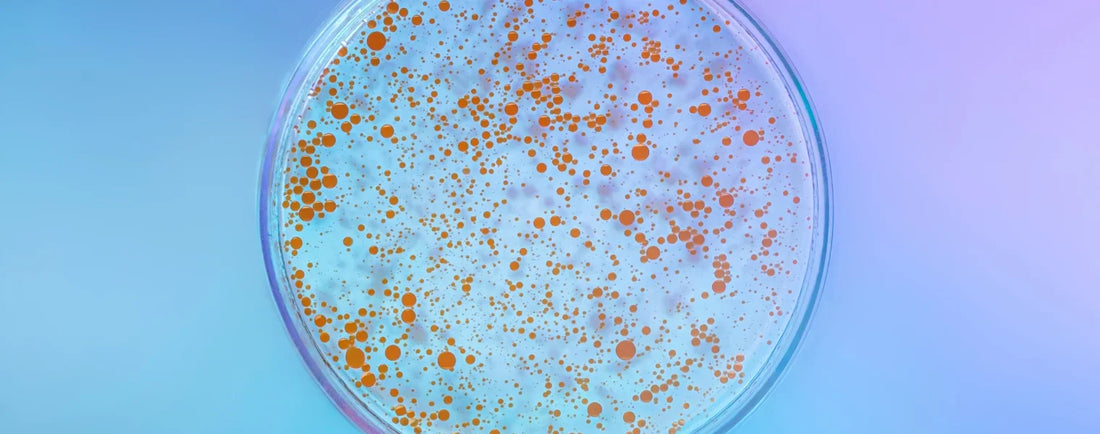
Comment améliorer l’hydratation de sa peau après 30 ans ?

Wie kann man die Hautfeuchtigkeit nach dem 30. Lebensjahr verbessern?
Spannungsgefühle, Trockenheitsfältchen, fahler Teint: Wir korrigieren sie mit einfachen Schritten und intelligenten Wirkstoffen.

Mit zunehmendem Alter speichert die Haut weniger Feuchtigkeit und ihre Schutzbarriere wird schwächer. Die gute Nachricht: Schon wenige gezielte Anpassungen genügen, um dauerhaftes Wohlbefinden und strahlende Haut zurückzugewinnen.
Warum trocknet die Haut mit zunehmendem Alter aus?
- Reduzierung der Talg- und Hyaluronsäureproduktion .
- Empfindlichere Hautbarriere → beschleunigte Wasserverdunstung .
- Exposom (UV-Strahlung, Umweltverschmutzung, Bildschirme) + Lebensstilrhythmen .
Der Hanloé-Tipp: Auch fettige Haut kann austrocknen . Reparieren Sie die Hautbarriere, pflegen Sie sie sanft mit Feuchtigkeit und vermeiden Sie aggressive Chemikalien.
Die richtigen Schritte zur Wiederherstellung der Flüssigkeitszufuhr
Sanft reinigen, ohne dabei zu scheuern.
- Sulfatfreie Formeln, physiologischer pH-Wert , gründlich abspülen.
- Maximal zwei Reinigungen pro Tag, kein kochendes Wasser.
Verwenden Sie eine gut formulierte Feuchtigkeitscreme.
- Hyaluronsäure (niedrige und mittlere Molekularmasse), Glycerin , Aloe Vera , Betain .
- Auf leicht feuchte Haut auftragen, um das Eindringen zu verbessern.
Feuchtigkeit einschließen
- Barrierecreme: Ceramide , Omega-Fettsäuren , Shea- oder Jojobaöl .
Natürliche Hautpflege wird ab 30 Jahren empfohlen.
Leichtes Feuchtigkeitsgel/Serum
Pflanzliche Hyaluronsäure, Betain, Aloe Vera.
Nährende Barrierecreme
Stärkt die Epidermis, geeignet für empfindliche Haut.
Wöchentliche Feuchtigkeitsmaske
Zur tiefenrevitalisierung der Haut.
Spezielle Augenkontur
Feine Gesichtspartie: sanfte Wirkstoffe + gezielte Feuchtigkeitsspender.

Innere Ernährung und Flüssigkeitszufuhr
- 1,5 Liter Wasser pro Tag (mehr bei Hitze/Sport).
- Wasserreiche Obst- und Gemüsesorten: Gurke, Melone, Wassermelone…
- Quellen für Omega-3- und Omega-6-Fettsäuren : fettreicher Fisch, Chiasamen, native Öle (Leinöl, Rapsöl, Leindotteröl).
Welche Hanloé-Hautpflegeprodukte werden ab 30 Jahren empfohlen?
- Tiefenwirksames Feuchtigkeitsserum/Gel – mit pflanzlicher Hyaluronsäure, Betain und Aloe Vera.
- Reparierende Barrierecreme – Ceramide & Omega-Fettsäuren.
- Sanfte AHA-Maske/Peeling – wöchentliche Anwendung.
Intelligente Feuchtigkeitsversorgung, langanhaltende Ausstrahlung
Setzen Sie auf die Erfolgsformel: Feuchtigkeitsspender + Barriere + sanfte Berührungen.
Entdecken Sie das Feuchtigkeitsgel. Sehen Sie sich die Barrierecreme an.